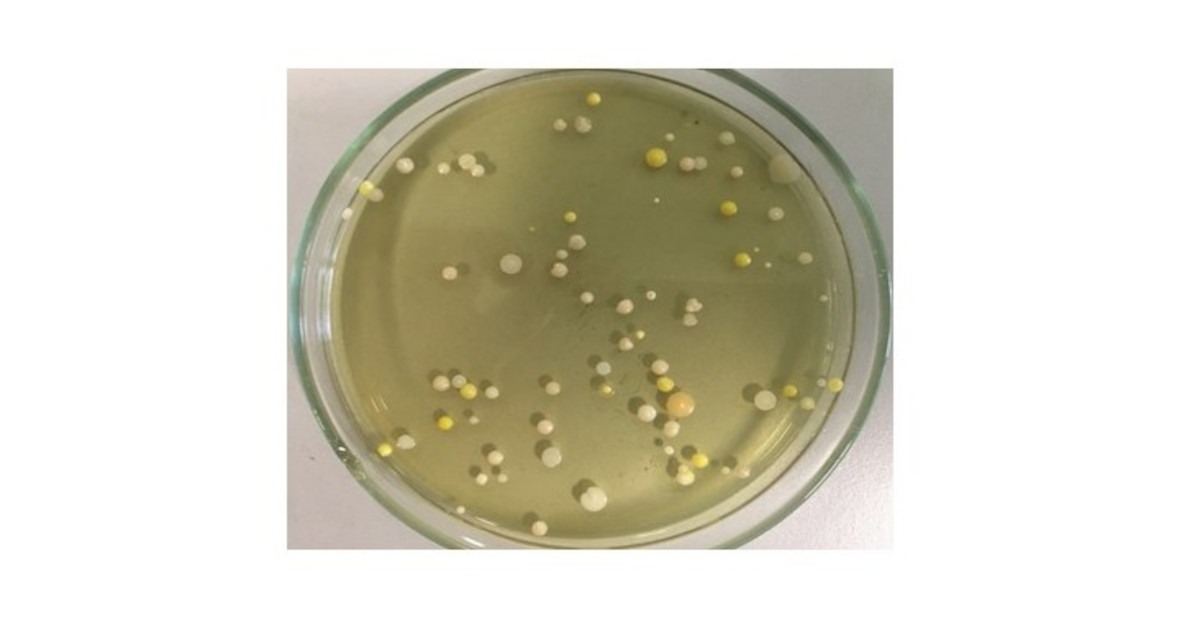
Graphical abstract

- 2.1Impact Factor
- 4.0CiteScore
- 17 daysTime to First Decision
Bacterial Symbionts of Invertebrates: Diversity, Transmission and Impacts
This special issue belongs to the section “Microbial Diversity and Culture Collections“.
Special Issue Information
Dear Colleagues,
We cordially invite you to contribute to this Special Issue of Diversity, entitled “Bacterial Symbionts of Invertebrate: Diversity, Transmission and Impacts”. Understanding the biology and ecology of invertebrate hosts requires an understanding of their bacterial associates. Symbiosis between bacterial symbionts (including endosymbionts) and a host can be beneficial to both partners. Animal hosts have evolved in a world teeming with microbes that play pivotal roles in their health, development, pathogen defense, nutrition, reproduction and evolution. Symbionts also influence invertebrate ecology, reproduction and evolution, promoting speciation, affecting ecological tolerances, etc. For example, over the course of evolution, bacterial symbionts may have induced several reproductive phenotypes in their hosts, including feminization, early and late male killing, parthenogenesis or cytoplasmic incompatibility. Prolonged and intimate associations between hosts and bacteria are ubiquitous in nature and occur in a variety of different forms; e.g., parasitic, commensal and mutualistic symbioses are widespread. Knowledge of this association currently allows applying the bacterial endosymbiont Wolbachia as a biocontrol agent for the transmission of arboviral infections such as Zika, dengue and other viruses by manipulating the reproduction of mosquito hosts.
Symbionts of invertebrates are represented by a variety of bacterial species, including culturable and unculturable microorganisms transmitted horizontally or vertically. These include Gram-positive and Gram-negative bacteria with different cell shapes, diverse genetic identities and phylogenetic relationships. Interestingly, the occurrence of (endo)symbionts in invertebrates is much more widespread than previously thought. This implies that more extensive sequencing may yield many more new infection cases in new host taxa, with the prospect of reversing our understanding of host-–bacterial species coevolution. This Special Issue aims to build a community of authors and readers documenting the latest research on the biodiversity of bacterial symbionts in invertebrates and the richness of interconnections between microbial organisms and their hosts.
Dr. Monika Mioduchowska
Dr. Edyta Konecka
Guest Editors
Manuscript Submission Information
Manuscripts should be submitted online at www.mdpi.com by registering and logging in to this website. Once you are registered, click here to go to the submission form. Manuscripts can be submitted until the deadline. All submissions that pass pre-check are peer-reviewed. Accepted papers will be published continuously in the journal (as soon as accepted) and will be listed together on the special issue website. Research articles, review articles as well as short communications are invited. For planned papers, a title and short abstract (about 250 words) can be sent to the Editorial Office for assessment.
Submitted manuscripts should not have been published previously, nor be under consideration for publication elsewhere (except conference proceedings papers). All manuscripts are thoroughly refereed through a single-blind peer-review process. A guide for authors and other relevant information for submission of manuscripts is available on the Instructions for Authors page. Diversity is an international peer-reviewed open access monthly journal published by MDPI.
Please visit the Instructions for Authors page before submitting a manuscript. The Article Processing Charge (APC) for publication in this open access journal is 2100 CHF (Swiss Francs). Submitted papers should be well formatted and use good English. Authors may use MDPI's English editing service prior to publication or during author revisions.
Keywords
- bacterial (endo)symbionts
- genetic diversity
- holobiont
- host–symbiont interaction
- metagenomics
- microbial ecology, communities and structure
- microbiome
- pathogenicity
- molecular evolution
- phylogeny
Benefits of Publishing in a Special Issue
- Ease of navigation: Grouping papers by topic helps scholars navigate broad scope journals more efficiently.
- Greater discoverability: Special Issues support the reach and impact of scientific research. Articles in Special Issues are more discoverable and cited more frequently.
- Expansion of research network: Special Issues facilitate connections among authors, fostering scientific collaborations.
- External promotion: Articles in Special Issues are often promoted through the journal's social media, increasing their visibility.
- e-Book format: Special Issues with more than 10 articles can be published as dedicated e-books, ensuring wide and rapid dissemination.

